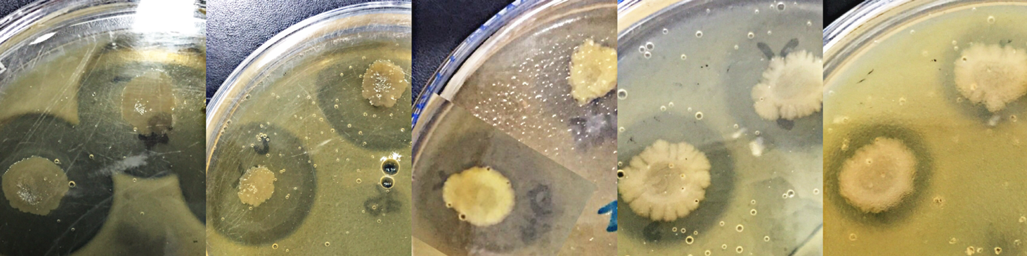
PSL%202019%20Special%20Issue%2007 Bertuso%20et%20al

Philipp. Sci. Lett. 2019 12 (Supplement) 081-090
available online: July 17, 2019
*Corresponding author
Email Address: nblantican@up.edu.ph
Date Received: February 15, 2019
Date Revised: May 12, 2019
Date Accepted: June 18, 2019
Alkaline proteases from alkaliphilic and alkalitolerant bacteria from Manleluag Hyperalkaline Spring in Pangasinan, Philippines
Protease is an enzyme that hydrolyzes peptide bonds of proteins and breaks them down into polypeptides or free amino acids. Proteases have applications in various industries such as the detergent, food, pharmaceutical, leather, and silk industries. This study was conducted to assess protease activities of alkaliphilic and alkalitolerant bacteria isolated from water, microbial mat, and sediment samples from Manleluag Hyperalkaline Spring by Skim Milk Assay (SMA) and by in-gel zymography. Of the 90 isolates obtained, 35 showed protease activity by SMA and were ranked according to their zone of clearing (Cz) ratio. The 5 isolates with the highest protease activities as determined by the lowest Cz ratio were SNE 3 (Cz 0.2908), SNE 2 (Cz 0.2971), SNE 9 (Cz 0.3338), W10 (Cz 0.3426), and W1 (Cz 0.3611). Molecular identification based on 16S rDNA sequencing showed closest identity of the 5 isolates to Bacillus pseudofirmus and B. marmarensis (99% similarity: SNE 3 and SNE 2), Cellulosimicrobium funkei and C. cellulans (99% similarity: SNE 9), and Bacillus hornekiae (96% similarity: W10 and W1), respectively. To determine if only one or more proteases were synthesized by the isolates, proteolytic activities under alkaline condition of crude enzyme extracts were visualized by zymography using gelatin and casein as substrates. Gelatinases and caseinases active in alkaline condition with different molecular weights (35 kDA up to <250 kDA) were detected. Strains isolated in this study present the potential for biotechnological uses.
© 2026 SciEnggJ
Philippine-American Academy of Science and Engineering